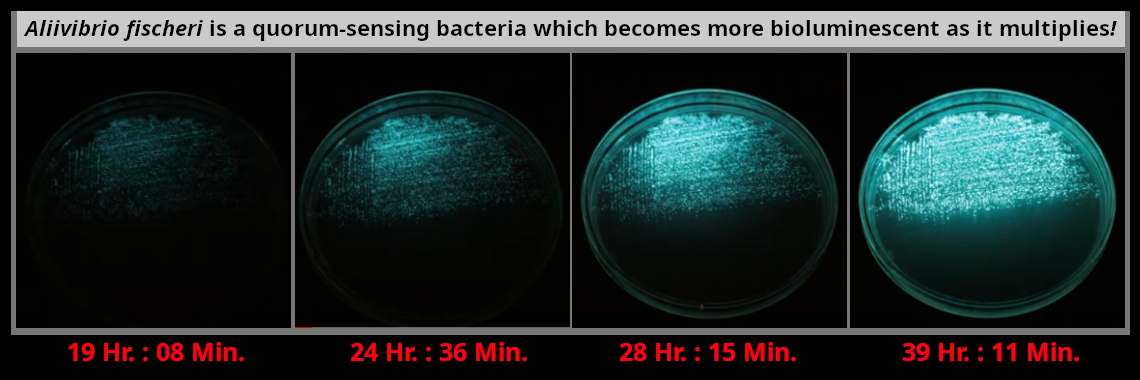

When Germs Find Strength in Numbers
Welcome to the Science of Quorum-Sensing Bacteria!
|
About the homepage photographs: Timer shows estimated [hours : minutes] of a 72 hour experiment. Photo credit: Christophe Veuillot, Feb. 4, 2020. |
The concept of virulence, often associated with germs, is closely tied to the number of infecting bacteria. The term virulence refers to the ability of a pathogen to cause disease, and it is indeed influenced by the quantity of the pathogen present.
The number of infecting bacteria plays a crucial role in determining the virulence of a pathogen. A small number of bacteria may not cause significant harm, while a large number can lead to severe illness. This is not just because the host’s immune system can effectively combat a small number of pathogens, but certain germs will only attack when they sense there are enough of them.
|
Quorum : the minimum number of officers or members of a body that is required to be present at a given meeting (as to transact business)i |
This is where “Quorum sensing” comes in. Quorum sensing is a process of bacterial cell-to-cell chemical communication, and it determines when beneficial bacteria change into pathogenic ones. Pathogens can coordinate their behavior and optimize their virulence in response to changes in their environment and the number of bacteria present. This process enables bacteria to express energetically expensive processes as a collective, only when the impact of those processes on the environment or on a host will be maximized.ii
When a bacterial population reaches a certain density, quorum sensing triggers the production of virulence factors, such as exotoxins, adhesins, and invasins, which enable the bacteria to colonize and infect host tissues. and even trigger the formation of biofilms, which are complex communities of bacteria that are protected from the host immune system.
|
Adhesin : Adhesins are cell-surface components or appendages of bacteria that facilitate adhesion or adherence to other cells or to surfaces, usually in the host they are infecting or living in. Adhesins are a type of virulence factor.iii |
|
|
|
Invasin : Invasins are a class of bacterial proteins associated with the penetration of pathogens into host cells. Invasins play a role in promoting entry during the initial stage of infection.iv |
|
|
|
Exotoxins are a type of toxin secreted by certain bacteria, which can cause harm to the host by destroying cells or disrupting normal cellular metabolism. They are highly potent and can cause significant damage to the host. |
Several pathogens use quorum sensing to adjust their virulence factors, including staphylococcus aureus, pseudomonas aeruginosa, vibrio cholerae.
|
Example: Staphylococcus aureus is a type of gram-positive bacteria that is commonly found on the skin and in the noses of many healthy people. It is a normal part of the human microbiota and is often present in the upper respiratory tract and on the skin. However, it can cause a wide range of infections, from minor skin infections to life-threatening conditions. When it senses a high population density, quorum sensing triggers the production of virulence factors, allowing it to cause more severe infections, such as sepsis and endocarditisv |
|
|
|
Microbiota refers to the diverse range of microorganisms that inhabit and interact with our bodies, including bacteria, archaea, protists, fungi, and viruses. These microorganisms play a crucial role in maintaining our health and well-being, and their imbalance or dysbiosis has been linked to various diseases.
Composition and Function: Microbiota can be found in various environments, including the human gut, skin, respiratory tract, and oral cavity. Each environment has its unique microbiota composition, which is shaped by factors such as diet, lifestyle, and genetics.vi |
Changes in the bodily environment, including the digestive tract, such as alterations in pH levels, oxygen levels, or the presence of toxins, can trigger a transformation from good to bad bacteria. Quorum sensing bacteria give off special signaling molecules called autoinducers. As the bacterial population density increases, the autoinducers become concentrated enough to be detected by the bacteria cells.
ihttps://www.merriam-webster.com/dictionary/quorum
iiRutherford ST, Bassler BL. Bacterial quorum sensing: its role in virulence and possibilities for its control. Cold Spring Harb Perspect Med. 2012 Nov 1;2(11):a012427. doi: 10.1101/cshperspect.a012427. PMID: 23125205; PMCID: PMC3543102.
iiihttps://en.wikipedia.org/wiki/Bacterial_adhesin
ivhttps://en.wikipedia.org/wiki/Invasin
vhttps://www.cdc.gov/staphylococcus-aureus/about/?CDC_AAref_Val=https://www.cdc.gov/hai/organisms/staph.html
